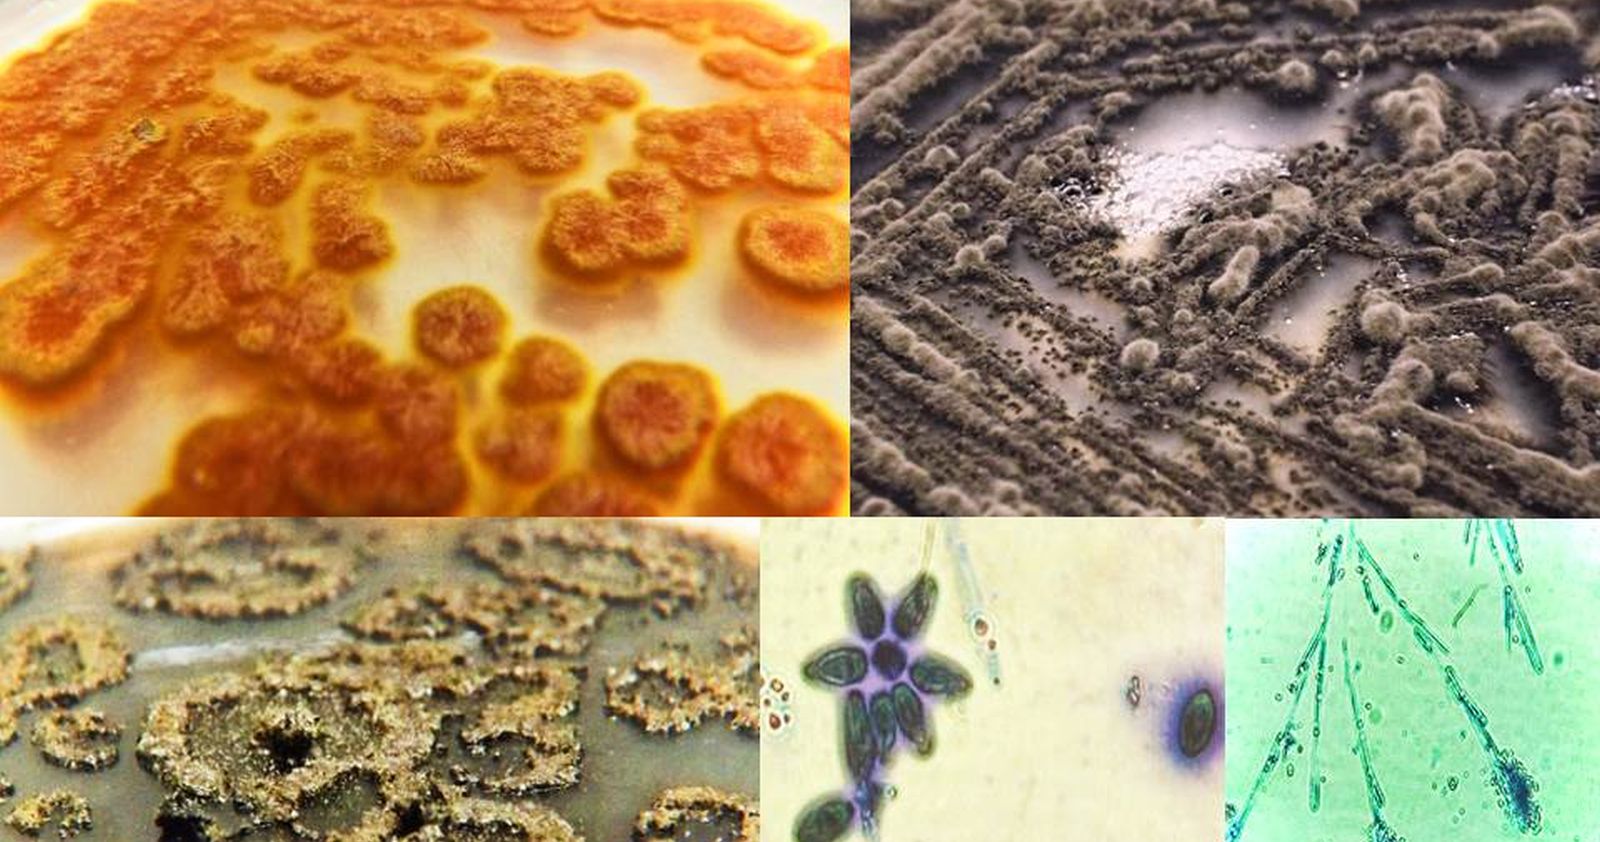

Una investigadora chilena seleccionó diversos hongos y algas marinas para desarrollar un superalimento que podría transformarse en una alternativa saludable y sustentable para la industria alimentaria.
Catalina Landeta, estudiante del doctorado en Ciencias de la Ingeniería e investigadora del Centro de Biotecnología y Bioingeniería (Cebib) de la Universidad de Chile, trabajó en una micoproteína que potencia en 60% sus proteínas y 42% de sus aminoácidos, incrementando la actividad antioxidante, características que lo hacen muy valoradas por la industria alimentaria.
El producto, llamado Micoseaweed, posee una alta concentración de aminoácidos y proteínas, una baja concentración de grasa y carbohidratos, y que adicionalmente tienen fibra y betaglucanos, junto con carbohidratos propios de las algas que son asimilables por los seres humanos y que ayudan a la microbiota de los seres humanos, que ayudan a tener una dieta más saludable.
“Estuvimos mucho tiempo investigando y analizando hongos, y nos dimos cuenta del potencial que tenían por sus concentraciones de proteínas y la calidad de sus aminoácidos. Ahí pudimos darnos cuenta que, si bien pueden ser utilizadas para la alimentación animal, también podían servir para la alimentación humana, considerando que existe una demanda creciente de fuentes de proteínas alternativas, sostenibles y con tecnologías de procesamiento sustentables, en un proceso de economía circular”, explicó Landaeta.
La científica señaló además que “las algas que utilizamos son del tipo grass y previamente son analizadas para que sean seguras para el consumo humano. Pero son las algas que normalmente consumimos, como el cochayuyo y las algas verdes que se conocen como lechuga de mar”.
El superalimento se desarrolla en un proceso que resulta amigable con el medio ambiente y con poco gasto energético No se utiliza tierra cultivable, ya que se puede hacer en tanques fermentadores (parecidos a los que se utilizan para la producción de cerveza), y tampoco requiere riego ni se utilizan fertilizantes.
Los siguientes pasos para poner Micoseaweed a disposición del público es la búsqueda de financiamiento para obtener una cantidad de producto mínimo viable, para así ir escalando a una planta piloto y empezar a procesar una mayor producción.






